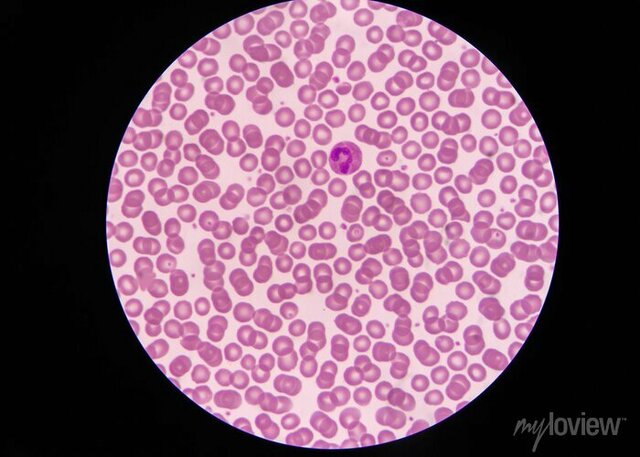
First blood microscope observation

-
 Exactly five centuries ago, on August 10, 1519, the navigator Fernand de Magellan took the start of the first world tour in history, at the head of a fleet of five ships and 237 men, the explorer will lose his life in this world tour.
Exactly five centuries ago, on August 10, 1519, the navigator Fernand de Magellan took the start of the first world tour in history, at the head of a fleet of five ships and 237 men, the explorer will lose his life in this world tour.
.
Fernand de Magellan launched his maritime journey to Seville, this world tour will last 3 years -
 Nicolas Copernic (Nicolaus Copernicus, 1473-1543) is a Polish astronomer known for his astronomical theory that the Sun is at the centre of the universe, the Earth circling around it. This is a system known as «heliocentrism» that theory will be accepted as true by the sleek only in 1820.
Nicolas Copernic (Nicolaus Copernicus, 1473-1543) is a Polish astronomer known for his astronomical theory that the Sun is at the centre of the universe, the Earth circling around it. This is a system known as «heliocentrism» that theory will be accepted as true by the sleek only in 1820. -
 Created by the Dutch optician Hans Janssen and his son Zacharias Janssen
Created by the Dutch optician Hans Janssen and his son Zacharias Janssen -
 The pascaline, originally called arithmetic machine then pascalin wheel, is a mechanical calculator invented by Blaise Pascalis a French mathematician, physicist, inventor, philosopher, moralist and theologian.
The pascaline, originally called arithmetic machine then pascalin wheel, is a mechanical calculator invented by Blaise Pascalis a French mathematician, physicist, inventor, philosopher, moralist and theologian.
Its considered as the first machine to calculate at the age of nineteen, that he conceived the idea 4, wanting to relieve the task of his father who had just been appointed superintendent of Upper Normandy. -
In 1658, the Dutch naturalist, Jan Swammerdam was the first person to observe red blood cells under a microscope.
In 1658, the Dutch naturalist, Jan Swammerdam was the first person to observe red blood cells under a microscope. -
 English mathematician and physicist Isaac Newton built a first version in 1672 of the PARABOLIQUE MICROSCOPE
English mathematician and physicist Isaac Newton built a first version in 1672 of the PARABOLIQUE MICROSCOPE -
 The mercury thermometer was invented by Daniel Gabriel Fahrenheit in 1724. Its operation is based on mercury contained in a glass tube. The volume of mercury, thus the length of the column in the tube, depends on its temperature.
The mercury thermometer was invented by Daniel Gabriel Fahrenheit in 1724. Its operation is based on mercury contained in a glass tube. The volume of mercury, thus the length of the column in the tube, depends on its temperature.
A list shows items. A timeline shows sequence.
Use Timetoast to make dates, milestones, and turning points easier to understand in a clear visual format. Timetoast is a timeline maker for work, school, research, and stories.